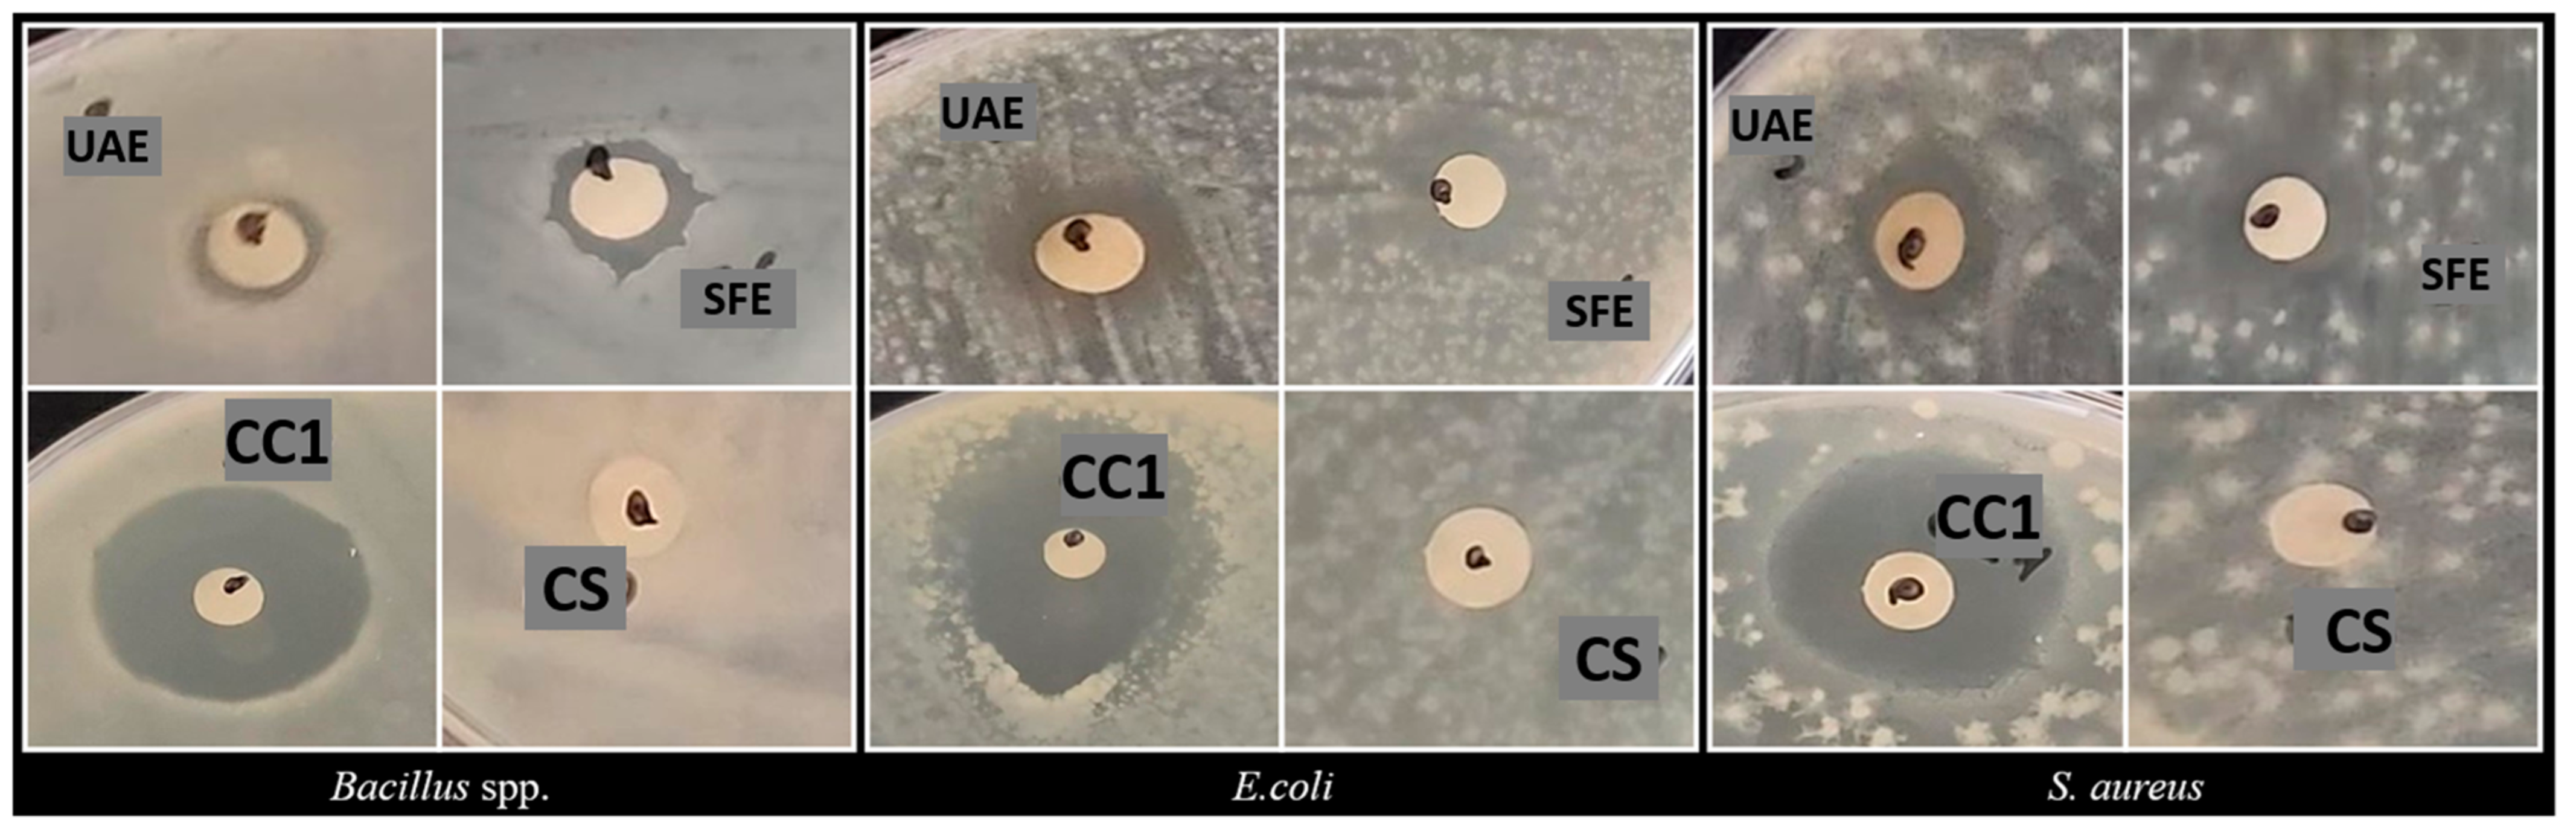
Separations 12 00008 g002

Abstract
This research paper investigates the phytochemical profile, antioxidant activity, antidiabetic potential, and antibacterial activity of Myrtus communis berries. Two extraction methods were employed to obtain the extracts: solid–liquid ultrasound-assisted extraction (UAE) and supercritical fluid extraction (SFE). The extracts were characterized using spectrophotometric methods and Reversed-Phase High-Performance Liquid Chromatography (RP-HPLC). The UAE extract exhibited higher total flavonoid and anthocyanin content, while the SFE extract prevailed in total phenolic content and antioxidant activity in the DPPH radical screening assay. RP-HPLC characterization identified and quantified several polyphenolic compounds. In the UAE extract, epigallocatechin was found in a concentration of 2656.24 ± 28.15 µg/g dry weight (DW). In the SFE extract, cafestol was the identified compound with the highest content at a level of 29.65 ± 0.03 µg/g DW. Both extracts contained several anthocyanin compounds, including cyanidin 3-O-glucoside chloride, cyanidin-3-O-rutinoside chloride, malvidin-3-O-glucoside chloride, pelargonidin 3-O-glucoside chloride, peonidin 3-O-glucoside chloride, and peonidin-3-O-rutinoside chloride. The antidiabetic potential was evaluated in vitro by measuring the inhibition of α-amylase from porcine pancreas (type I-A). The results highlighted the ability of myrtle berry extracts to inhibit α-amylase enzymatic activity, suggesting its potential as an alternative for controlling postprandial hyperglycemia. The UAE extract showed the lowest IC50 value among the two extracts, with an average of 8.37 ± 0.52 µg/mL DW. The antibacterial activity of the extracts was assessed in vitro against Bacillus spp., Escherichia coli, and Staphylococcus aureus using the disk diffusion method. Both myrtle berry extracts exhibited similar antibacterial activity against the tested bacterial strains. The results support further investigation of myrtle berries extracts as a potential ingredient in functional food formulation, particularly due to its antioxidant, antidiabetic, and antibacterial properties.
1. Introduction
Among the medicinal and aromatic plants, the myrtle (Myrtus communis L.; Myrtaceae family) can be found in the Mediterranean region, but it also grows in West Asia, the Northwestern Himalayas, South America, and Australia [1]. This evergreen shrub can reach a height of up to 3 m and features ovate or lanceolate leaves that are 3–5 cm long. It produces white or pink flowers and spherical berries that can be blue-black or white-yellow, containing seeds that mature between October and February [2,3]. Myrtle can adapt to challenging environmental parameters, but it is sensitive to cold winds [4]. Myrtle has various applications, including traditional medicine, perfumery, cosmetic, and as a spice in food preparation in specific regions [3]. One notable product is Myrto, a sweet liquor with digestive properties produced in Sardinia, Italy, through the alcoholic maceration of myrtle berries [5]. Researchers have shown increasing interest in the berries and leaves of myrtle to explore their potential uses for packaging films for food application [6,7], pharmaceutical products [8,9,10,11], and as dietary supplement in the veterinary sector [12]. Several studies have highlighted the bioactivity of myrtle, including its antioxidant, antimicrobial, anti-inflammatory, anticancer, antidiabetic, antimutagenic, cardiovascular, activity against hepatic ischemia, and insecticidal properties [13,14]. The health-promoting effects of myrtle berries and leaves are owed to bioactive compounds such as phenolic compounds, flavonoids, anthocyanins (found in the berries), tannins, coumarins, essential oils (terpenoids in particular, α-pinene, 1,8-cineole, geranyl acetate, linalool), and fatty acids (linoleic, palmitic, oleic, stearic acids) [1,3,15].
Distillation, alcoholic or aqueous maceration, and Soxhlet extraction are traditional methods used to extract phytochemical compounds from plants, often involving solvents. These methods typically require a significant amount of energy and solvents, are time-consuming, can degrade sensitive compounds, and tend to have a higher environmental impact. In contrast, more advanced extraction methods like ultrasound, microwave, enzymatic, pulsed electric field, and supercritical or subcritical fluid are employed to achieve higher extraction yields in shorter extraction periods. These methods are more suitable for thermo-sensitive compounds and are considered “green” due to their reduced energy and solvent consumption, as well as their lower environmental impact [16,17].
The ultrasound-assisted extraction method uses waves above 20 kHz to create a series of compression and rarefaction cycles transmitted into the media. This process leads to the formation and subsequent destructive collapse of bubbles, generating extreme mechanical forces that enhance the diffusion of phytochemical compounds from the plant matrix into the solvent. This extraction method is cost-effective, can be adapted for both small- and large-scale production, requires less solvent volume to extract a higher volume of sample, reduces extraction time, and yields higher extraction efficiency. However, a long treatment period could negatively affect the extraction by decreasing the diffusion rate and degrading sensitive compounds [18,19,20,21].
The supercritical fluid extraction method involves the use of fluids above their specific critical point. Carbon dioxide (CO2) is the most widely used supercritical fluid due to its low critical temperature (31.1 °C) and pressure (7.38 MPa), along with its non-toxicity, non-flammability, and affordability [22]. Temperature and pressure directly influence the solubility properties of CO2. Supercritical CO2 (SC-CO2) has low viscosity and high diffusivity, which allows it to penetrate plant matrices effectively. This makes it particularly efficient for extracting lipid compounds, although it is not effective for polar compounds. However, since one of the limitations of SC-CO2 extraction in the insolubility of polar molecules, the addition of a small amount of a miscible polar modifier can change the properties of the crude solvent and increase its capability to solubilize polar compounds [23] such as phenols and carotenoids. The most commonly reported co-solvents include ethanol, methanol, water [24], or a mixture of ethanol–water. The advantages of the SC-CO2 extraction method are is environment-friendly process, being non-oxidative for sensitive compounds, its solventless extracts, its high selectivity, its recycling operations resulting in reduced costs, and easy control of its extraction parameters. Disadvantages of SC-CO2 technologies include their low extraction yield, not being suitable for polar compound extraction, and having high capital investment [18,25,26].
The potential of wild myrtle berries in developing functional food products could be explored by eco-friendly extraction methods ensuring that the extracts are safe for consumption. Therefore, UAE and SFE methods were applied to obtain extracts from myrtle berries collected in Albania. The obtained extracts were analyzed for their phytochemical profile, antioxidant potential, antidiabetic properties, and antimicrobial activity. The phytochemical profile of the extracts was evaluated using spectrophotometric methods and RP-HPLC. The antimicrobial potential was tested against bacterial strains that present significant challenges in the food sector. In vitro assessments were conducted using standard laboratory control strains, as well as isolated bacterial strains from Industrial Microorganisms of the University of Galați “Dunărea de Jos” Collection (MIUG).
2. Materials and Methods
2.1. Plant Materials
Wild myrtle berries were gathered in Seman, Fier, Albania (40°46′01.9″ N 19°22′43.5″ E) in December 2022. A specimen of the sample was identified by Prof. Dr. Lulëzim Shuka from the Department of Biology at the Faculty of Natural Science, University of Tirana, Albania. The berries were cleaned of impurities and dried in room temperature conditions. At the end of the drying process, the myrtle berries exhibited a moisture content of 15.64 ± 0.01%, which was measured using a moisture analyzer (KERN; DAB 100-3; Balingen, Germany), and recorded a water activity of 0.52 ± 0.00 aw, which was measured by a water activity meter (Fast-lab; GBX Scientific Ltd.; Romans sur Isére Cédex, France). The results for moisture content and water activity of the dried berries are reported as average values for duplicate measurements ± STDEV.
2.2. Reagents
The following chemical reagents were purchased from Sigma-Aldrich (Steinheim, Germany): DPPH (2,2-diphenyl-1-picrylhydrazyl), aluminum chloride (AlCl3), sodium carbonate (Na2CO3), potassium chloride (KCl), sodium acetate (CH3COONa), α-amylase from porcine pancreas (type I-A, 700–1400 U/mg protein), starch, dinitrosalicylic acid (DNS), reagents for phosphate buffer solution (PBS), dimethyl sulfoxide (DMSO), Brain Heart Infusion Broth (BHI Broth), Nutrient Agar Media, and standard compounds for spectrophotometric and RP-HPLC characterization. Ciprofloxacin hydrochloride was obtained from AppliChem (Darmstadt, Germany). Methanol, formic acid, acetonitrile, and ethyl acetate of HPLC grade were purchased from Honeywell (Seelze, Germany). Methanol, ethanol, acetone, and glacial acetic acid were purchased from S.C. Chimreactiv, S.R.L. (Bucharest, Romania), while Folin–Ciocâlteu chemical reagent was obtained from Remed Prodimpex S.R.L. (Bucharest, Romania). Tanks with 99.99% pure CO2 were supplied by Messer S.A. (Bucharest, Romania). Ultrapure water (0.058 µS/cm) was secured from a water purification system (Mod. SMART N-II, Heal Force; Shanghai, China).
2.3. Ultrasound-Assisted Extraction
The dried wild myrtle berries were ground in an electric grinder (Heinner HCG-150SS, Bucharest, Romania) and extracted using a digital ultrasonic bath (Mod. DU-32; ARGOLAB, Capri, Italy). Medda et al. [27] applied acidified ethanol with hydrochloric acid (HCl) to extract and characterize the bioactive compounds from myrtle berries. However, since the focus of this work is to obtain extracts safe to be utilized in the food industry, HCl was substituted with acetic acid, and a final mixture composed of ethanol, ultrapure water, and acetic acid (63:27:10, v/v/v) was used to extract the bioactive compounds from the myrtle berries. The extraction process consisted of a solid–liquid (1:10 plant:solvent ratio w/v), triple-stage, batch extraction at 25 °C, 40 kHz ultrasound frequency, for 15 min. The extracts were centrifuged at 6500× g rpm, for 10 min at 4 °C (Universal 320R Centrifuge, Hettich; Germany), and for the concentration of the supernatant, we used a rotary vacuum concentrator equipped with a vacuum pump and cooling trap (RVC 2-18 CDplus and CT02-50, Martin Christ, Osterode am Harz, Germany). The concentrated extract was stored at 4 °C until further investigation. The extraction yield was determined gravimetrically based on the weight of the raw sample used for extraction and the weight of the extract obtained after the concentration process, expressed in percentage (% g/g).
2.4. Supercritical Fluid Extraction
The supercritical extraction, applying CO2 as supercritical fluid, was performed in a pilot plant extractor (Natex, Prozesstechnologie GesmbH, Fabr. no. 10-023/2011, Ternitz, Austria) equipped with a 2.0 L stainless steel extractor and two separators (S40 and S45) with a volume of 1.5 L each, which are described elsewhere [28]. In our experiment, 240 g of dry sample was grinded with a manual grinder (Heinner HCG-150SS; Bucharest, Romania). To modify the polarity of the SFE of bioactive compounds from wild myrtle berries, a 20% w/w [29] of the mixture of ethanol–water (7:3 v/v) was incorporating directly onto the material, and Raschig rings (1:1 ratio w/w) were added before loading into the extractor. Idris et al.’s [30] studies concluded that when water (10–30% v/v) was added to ethanol as co-solvent, the overall yield was increased. Duran et al. [31] concluded that in the case of phenolic compounds extraction, water and ethanol might have a synergetic effect increasing the extraction yield: water solubilizes the polar compounds because of its higher polarity than ethanol (which can lead to greater solubilization of phenolic compounds). The extraction conditions were adapted from the literature [32,33] and consisted of the extraction temperature of 45 °C, pressure of 23 MPa, and extraction time of 2 h. The solvent was constantly cooled down at −3.5 °C by means of a cooler to remain liquid and then compressed up to the desired operation working pressure. The solvent was pressurized and heated up to the desired temperature, and during extraction experiment, it was recirculated. Our SFE pilot plant allowed us to obtain two extract fractions with different compositions by pressure and temperature modification. In our experiments, for first separator S40, the parameters were 45 °C/15 MPa and for second separator S45 were 21 °C/5 MPa. The supercritical CO2 flow rate was 20 kg·h−1, and all the extraction parameters were automatically controlled and indicated by ABB software Freelance 9.2 (ABB, Mannheim, Germany). After depressurization of the separators, the extracts were collected, and ethanol was removed by evaporation in a vacuum concentrator (RVC 2-18 CDplus and CT02-50, Martin Christ, Osterode am Harz, Germany) until dry. The concentrated extract was stored and kept in dark containers at 4 °C until further investigation. The extraction yield was determined gravimetrically based on the weight of the raw sample loaded in the extraction cylinder and the weight of the both fractions extract, reported in percentage (% g/g) [34].
2.5. Global Phytochemical Characterization
The global phytochemical characterization was estimated by colorimetric spectrophotometric means using a UV/visible spectrophotometer (Biochrom, Libra 22, Holliston, MA, USA). The concentrated extracts from UAE and SFE were redissolved in ethanol 70% (v/v), and the results are reported as average values for triplicate measurements ± STDEV.
The total phenolic content (TPC) was measured using the Folin–Ciocâlteu reagent and Na2CO3 20% (w/v) protocol [35], with the absorbance read at 765 nm. The results were calculated based on a calibration equation and reported in milligrams of gallic acid equivalents per gram of dry weight (mg GAE/g DW).
The protocol for the total flavonoid content (TFC) consisted of mixing 250 µL of sample with 250 µL of AlCl3 2% methanolic solution (w/v) and 1500 µL of methanol. After 15 min in darkness, the absorbance was measured at 440 nm [36]. The results were calculated based on a calibration equation, reported in milligrams of quercetin equivalents per gram of dry weight (mg QE/g DW).
Total anthocyanins content (TAC) was determinate based on the pH differential protocol [35], which consisted of utilizing KCl buffer (0.025 M; pH = 1.0) and CH3COONa buffer (0.4 M; pH = 4.5), with the absorbances measured at 520 and 700 nm. The results were calculated based on Equation (1), reported as milligrams of cyanidin 3-O-glucoside per gram of dry weight (mg C3G/g DW):
where Abs is the measured absorbance; MW is the molecular weight of cyanidin 3-O-glucoside (484.8 g/mol [37]); V is the volume of the analyzed extract (mL); ε is the molar absorptivity of cyanidin 3-O-glucoside (26,900 L mol−1 cm−1); m is the weight of the concentrated extract (g).
2.6. Antioxidant Activity
The antioxidant activity of the concentrated UAE and SFE extracts, redissolved in ethanol 70% (v/v), was assessed using a DPPH radical scavenging assay [38]. A volume of 100 µL of the sample was mixed with 3900 µL of DPPH methanolic solution (0.004%, w/v) and incubated in the dark for 30 min. The absorbance was measured at 515 nm. The results were calculated based on a calibration equation and reported as average values for triplicate measurements ± STDEV in milligrams of Trolox equivalent per gram of dry weight (mg TE/g DW).
2.7. Reversed-Phase High-Performance Liquid Chromatography (RP-HPLC) Characterization
The polyphenolic and lipophilic compounds present in the UAE and SFE extracts were determined using an Agilent 1200 HPLC system with a provided autosampler, degasser, quaternary pump system, multi-wavelength detector, and column thermostat (Agilent Technologies, Santa Clara, CA, USA). The separation conditions for the polyphenolic compounds involved a binary elution system consisting of 99.9% methanol (v/v) (solvent A) and 10% formic acid in ultrapure water (v/v) (solvent B) read at 280 nm, 320 nm, and 520 nm for anthocyanins using BDS Hypersil C18 column (150 × 4.6 mm, 5 μm). The concentrated extracts were redissolved in methanol and filtered using nylon syringe filters (0.20 µm). A 10 μL injection volume was analyzed under the following operating parameters: flow rate of 1 mL/min and temperature of 30 °C. The separation of the lipophilic compounds was conducted using 99.5% ethyl acetate (v/v) (solvent A), and 90% acetonitrile in ultrapure water (v/v) (solvent B), equipped with a Lichrosorb RP-18 (5 μm) Hibar RT 125-4 column, and read at 450 nm. Additionally, a 10 μL injection volume of the filtered concentrated extracts, redissolved in ethyl acetate, was analyzed under operating conditions of 0.800 mL/min flow rate at 30 °C. The quantified results for the identified compounds were calculated based on the peak area and calibration curves with reference standards, reported as average values for duplicate measurements ± STDEV in micrograms per gram of dry weight (µg/g DW).
2.8. In Vitro Antidiabetic Activity
The in vitro antidiabetic activity of the extracts was evaluated by measuring the inhibition of α-amylase enzymatic activity following the methodology described in the study by Serea et al. [39]. The concentrated extracts were resuspended in DMSO to achieve final concentrations of 3.33, 6.66, 10.00, 13.33, and 16.66 µg/mL DW for the assay. To eliminate the influence of the extract color, sample absorbance was measured against a calibration sample that did not contain the enzyme. The inhibitory activity of the extracts was assessed using a UV/visible spectrophotometer (Biochrom, Libra 22, Holliston, MA, USA). The percentage of inhibition was calculated based on Equation (2) and expressed as average values from duplicate measurements ± standard deviation. The IC50 value, which indicates the concentration required to inhibit 50% of the enzymatic activity, was determined from the linear regression equation derived from the inhibition activity of the extracts and reported as average values ± STDEV in micrograms of milliliters of dry weight (µg/mL DW):
where Absc is the absorbance value obtained from the control sample containing only enzyme, and Abss is the absorbance value obtained from the tested sample.
2.9. In Vitro Antibacterial Activity
The in vitro antimicrobial activity of the extracts was performed on Escherichia coli (ATCC 25922), Staphylococcus aureus (ATCC 25923), and Bacillus spp. (spore-forming bacterial strain), which are part of the MIUG collection. The bacterial strains were reactivated in sterile BHI broth and incubated overnight at 37 °C. The overnight culture was diluted, and the colony forming units (CFUs) were measured by optical density at 600 nm (JENWAY Spectrophotometer, Model 6505 UV-Vis, Great Dunmow, UK).
The concentrated extracts from UAE and SFE were dissolved in 25% acetone (v/v), with a final concentration of 50 mg/mL, and filtered in sterile conditions using special filters (0.20 µm). The extract concentration and the solubilization solution were chosen to improve the solubility of the extracts, as proposed in the literature [40,41].
For the disk diffusion method, a sterile swab was used to spread 100 µL of 107 CFU/mL of inoculum on a Petri dish with solidified nutrient agar media. A volume of 10 µL of extract was pipetted to a sterile 6.00 mm paper disk placed on the solidified nutrient agar media [42]. Ciprofloxacin (1 mg/mL) was used as a positive control, and the solubilization solvent was used as a negative control. The Petri dishes were incubated at 37 °C for 24 h, the inhibition diameters were measured, and the results are expressed as mean ± standard deviation for duplicate tests in millimeters per diameter of inhibition zone (mm DIZ).
2.10. Statistical Evaluation
The differences between the extracts from different extraction methods were analyzed by performing the one-way ANOVA method. The data were checked for normality distribution (Ryan–Joiner test) and equality of the variances (Bartlett’s test), followed by Tukey test (p > 0.01) or Games–Howell test (p < 0.01) and 99% confidence. The statistical interpretation was accomplished in Minitab Software Version 19.1 for Windows.
3. Results
3.1. Extraction Yield and Global Characterization of the Myrtle Berries Extracts
Two emerging extraction methods were used to obtain extract from wild myrtle berries. Table 1 presents the extraction yield, the global phytochemical characterization, and the antioxidant activity of the extracts. From the UAE extract, the combination of ethanol–water–acetic acid as solvents resulted in an extraction yield of 62.84%. Regarding the SFE extract, to the best of our knowledge, the application of the ternary system for extraction of the bioactive from the myrtle berries has not been explored. In the SFE extract, Idris et al. [30] reported the influence of 30% water content in ethanol with modification of the plant matrix and enhancement of the coextraction of less-polar or polar compounds. They reported for the leaves of Gynura procumbens the highest yield at 24 MPa and 30% water in ethanol for both studied temperatures. In our experiments, the SFE yield obtained was 0.54% for both fractions obtained from separator S40 and S45. The smaller extract quantity (approximately 8.13% of the total concentrated extract) was obtained from separator S40, as this fraction separates volatile compounds with low molecular weight. Pereira et al. [32] reported higher extraction yields for myrtle berries collected from Portugal in October 2006–2008, which they extracted using the binary system (CO2 and ethanol). These differences could be motivated by the influence of climatic factors and the extraction conditions. In the SFE process, we used 7:3 (v/v) ethanol–water as the co-solvent to identify the gallic acid and quercetin in the SFE extract (Table 2). These results agree with Pereira et al. [32].
Table 1.
Extraction yield, global characterization, and antioxidant activity of the myrtle berries extracts.
Spectrophotometric characterization revealed that the SFE extract exhibited a higher TPC compared to the UAE extract, with values of 11.59 ± 0.12 mg GAE/g DW and 5.57 ± 0.13 mg GAE/g DW, respectively. The results suggest that the TPC influences the antioxidant properties of the samples. The SFE extract demonstrated greater antioxidant activity against the DPPH radical screening assay, with an average of 21.81 ± 0.31 mg TE/g DW, while the UAE extract presented an antioxidant activity of 13.64 ± 1.91 mg TE/g DW. However, the UAE extract had a higher TFC of 4.13 ± 0.67 mg QE/g DW. Additionally, anthocyanins were only detected in the UAE extract, with a content of 2.17 ± 0.05 mg C3G/g DW.
3.2. RP-HPLC Characterization of the Myrtle Berries Extracts
Table 2 presents the polyphenolic and lipophilic phytochemical compounds identified through RP-HPLC characterization. The myrtle berry extract obtained from UAE exhibited a higher number of identified polyphenolic compounds, with epigallocatechin showing the highest concentration in the extract at an average of 2656.24 ± 28.15 µg/g DW, followed by cafestol at 256.92 ± 5.33 µg/g DW. Among the identified and quantified anthocyanins, cyanidin-3-O-rutinoside chloride was most prevalent in the UAE extract, with a concentration of 36.09 ± 0.07 µg/g DW. In contrast, cafestol was the most concentrated compound in the SFE extract, with a content of 29.65 ± 0.03 µg/g DW. Additionally, malvidin-3-O-glucoside chloride was the anthocyanin with the highest concentration in the SFE extract at a content of 0.66 ± 0.04 µg/g DW.
Table 2.
RP-HPLC characterization of the myrtle berries extracts.
Table 2.
RP-HPLC characterization of the myrtle berries extracts.
| Identified Compounds | UAE | SFE |
|---|---|---|
| Phenolic acids | ||
| 4-Hydroxybenzoic acid | 24.00 ± 0.03 G | n.d. |
| Caffeic acid | 0.63 ± 0.03 R | n.d. |
| Ferulic acid | 3.69 ± 0.31 M | 0.30 ± 0.03 I |
| Gallic acid | 11.64 ± 0.03 I | 1.70 ± 0.73 B |
| Protocatechuic acid | 24.45 ± 0.01 F | n.d. |
| Sinapic acid | 2.17 ± 0.10 P | 1.29 ± 0.14 C |
| Terpenoid | ||
| Cafestol | 256.92 ± 5.33 B | 29.65 ± 0.03 A |
| Flavonoid | ||
| Apigenin | 3.73 ± 0.03 L | n.d. |
| Epicatechin | 14.39 ± 0.01 H | n.d. |
| Epicatechin gallate | 79.73 ± 0.04 C | n.d. |
| Epigallocatechin | 2656.24 ± 28.15 A | n.d. |
| Naringin | 7.00 ± 0.04 J | n.d. |
| Quercetin | 0.66 ± 0.16 Q | 0.60 ± 0.03 F |
| Rutin trihydrate (Quercetin-3-rutinoside trihydrate) | 25.55 ± 0.49 E | n.d. |
| Anthocyanins | ||
| Cyanidin 3-O-glucoside chloride (Kuromanin chloride) | 3.94 ± 0.01 K | 0.41 ± 0.01 H |
| Cyanidin-3-O-rutinoside chloride (Keracyanin chloride) | 36.09 ± 0.07 D | 0.62 ± 0.01 E |
| Malvidin-3-O-glucoside chloride (Oenin chloride) | n.d. | 0.66 ± 0.04 D |
| Pelargonidin 3-O-glucoside chloride (Callistephin chloride) | n.d. | 0.55 ± 0.11 G |
| Peonidin 3-O-glucoside chloride | 3.44 ± 1.36 N | n.d. |
| Peonidin-3-O-rutinoside chloride | 3.05 ± 0.01 O | n.d. |
| Carotenoids | ||
| Zeaxanthin | n.d. | 0.28 ± 0.02 J |
n.d.—Not detected. Uppercase letters in the same column are used for statistical comparisons between the different compounds for one extraction method. Means that do not share a letter are significantly different based on the Games–Howell test (p < 0.01).
The results indicate that the UAE method yields a greater variety and concentration of bioactive compounds. Notably, compounds such as 4-hydroxybenzoic acid, caffeic acid, protocatechuic acid, apigenin, epicatechin, epicatechin gallate, epigallocatechin, and naringin were detected exclusively in the UAE extract. Furthermore, compounds found in both extracts such as ferulic acid, gallic acid, sinapic acid, cafestol, quercetin, and various anthocyanins exhibited higher concentrations in the UAE extract.
The chromatograms presented in Figure 1a–e indicate a diverse polyphenolic profile of myrtle berries extract, and lipophilic compounds in the case of the SFE extract, with different peaks detected at the specific wavelengths. However, several peaks could not be identified due to the absence of corresponding references with the standard compounds in our research center’s RP-HPLC system database.
Figure 1.
Chromatograms of wild myrtle berries extracts. UAE extract: (a) 280 nm; 2—gallic acid; 5—epicatechin; 8—ferulic acid; 10—synapic acid; 1, 3, 4, 6, 7, 9, 11–17—unidentified compounds. (b) 520 nm; 2—gallic acid; 7—kuromanin chloride; 8—synapic acid; 10—naringin; 11—rutin trihydrate; 12—peonidin-3-O-rutinoside chloride; 15—quercetin; 1, 3–6, 9, 13, 14, 16—unidentified compounds. SFE extract: (c) 280 nm; 1—cafestol; 2—gallic acid; 7—ferulic acid; 16—quercetin; 3–6, 8–15—unidentified compounds. (d) 520 nm; 4—kuromanin chloride; 5—callistephin chloride; 9—oenin chloride; 1–3, 6–8, 10–17—unidentified compounds. (e) 450 nm: 8—zeaxanthin; 1–7, 9–11—unidentified compounds.
3.3. Antidiabetic Activity of the Myrtle Berries Extracts
Table 3 presents the percentage of inhibitory activity of the myrtle berries extracts against α-amylase, as well as the concentration required to inhibit 50% of the enzymatic activity. The results indicate that both the UAE and SFE extracts demonstrated increased α-amylase inhibition with higher extract concentrations, demonstrating a dose-dependent effect. At a lower extract concentration (3.33 µg/mL DW), the difference in enzymatic inhibition rates between the two extracts was not significant. However, as the concentration increased, the inhibitory effect of the UAE extract became more pronounced. The sharp rise in the inhibition rate suggests that the phytochemical composition of the UAE extract has a significant biological impact on α-amylase activity, resulting in a lower IC50 of 8.37 ± 0.52 µg/mL DW. In contrast, a higher concentration of the SFE extract (IC50 = 27.27 ± 1.31 µg/mL DW) was necessary to achieve a similar inhibitory effect. The common drug used in the treatment of diabetes is acarbose. Serea et al. [39] reported an IC50 value for acarbose of 3.91 ± 0.44 µg/mL, which is lower than both values reported in this study for the myrtle berries extracts.
Table 3.
Inhibitory activity of the extracts against α-amylase.
3.4. Antibacterial Activity
The antibacterial activity of myrtle berries extracts is presented in Table 4 and Figure 2. The statistical evaluation did not show significant differences in the diameter of inhibition zone between the UAE and SFE extracts for the same bacterial strain. However, S. aureus was observed as being the most sensitive bacterial strain against UAE extract antibacterial activity, with an average of 12.00 ± 2.82 mm DIZ. Meanwhile, for the SFE extract, the most sensitive out of the three bacterial strains was E. coli, with a 13.00 ± 0.03 mm DIZ. In both cases, Bacillus spp. was the least sensitive bacterial strain, showing a lower diameter of inhibition zone against the UAE and SFE extracts (9.00 ± 0.02 mm and 11.50 ± 0.71 mm, respectively).
Table 4.
Results of antibacterial activity using disk diffusion method.
Figure 2.
Antibacterial results of disk diffusion method against the tested bacterial strains. The samples codes represent the following: UAE—myrtle berries extract from ultrasound-assisted extraction; SFE—myrtle berries extract extract from supercritical fluid extraction; CC1—ciprofloxacin (positive control); CS—solubilization solvent (negative control).
4. Discussion
The yield obtained from the solid–liquid ultrasound-assisted extraction of myrtle berries in this study was higher than that reported in the literature, where most extractions were performed using the maceration method. For instance, Pereira et al. [43] reported a gravimetric yield of 8.52 ± 0.01% from ethanolic ultrasound-assisted maceration of myrtle berries. In another study, Babou et al. [44] obtained yields of 15.71% and 36.86% from methanolic extraction conducted during September and December, respectively, from myrtle berries (M. communis var. italica) collected in Algeria, while the aqueous extract showed yields of 21.74%, and 35.38% for September and December berries, respectively.
In their study, Pereira et al. [32] reported that using supercritical CO2 extraction for myrtle berries resulted in extraction yields ranging from 8.8 ± 0.5% to 14.1 ± 0.9%, which are higher compared to the extraction yield obtained in our supercritical fluid pilot plant extractor. In another study [45] using hydro distillation with a Clevenger apparatus on myrtle berries collected in Croatia, the authors reported an extraction yield for the essential oils varying from 0.03 to 0.13% (w/w). The authors noted that the essential oil yield reached its peak in October and decreased rapidly thereafter. The yields of extracts and essential oils can be significantly influenced by factors such as the extraction conditions, the solvent used, and the season of collection. Also, these factors influence the final phytochemical composition of the extracts and essential oils.
In the study conducted by Medda et al. [27], myrtle berry extracts obtained through maceration with acidified ethanol (0.1% HCl) were collected from various varieties and altitudes in Sardinia. The TPC ranged from 33.46 to 35.43 mg GAE/g DW. The highest TAC in the berries was observed in the second week of December, with values varying from 14.02 to 34.20 mg C3G/g DW—depending on the berry’s cultivar and geographical location. It was noted that while the TPC decreased, the TAC increased during the maturation of the berries. Amensour et al. [46] noted a TPC of 14.7 ± 0.4 mg GAE/g of extract for methanol, 9.0 ± 0.2 mg GAE/g for ethanol, and 15.7 ± 0.7 mg GAE/g for aqueous extract from myrtle berries collected in Morocco. The authors noted that the extraction yield of phenolic compounds increased with the polarity of the solvents, with the aqueous extract exhibiting the highest TPC and the ethanol extract showing the lowest. Curiel et al. [47] reported a TPC of 135.49 ± 2.35 mg GAE/g of DW from an acidified aqueous homogenate of myrtle berries. Polat et al. [48] explored different extraction solvents to isolate bioactive compounds from myrtle berries collected from various locations in Mersin, Turkey. Their findings indicated that the TPC for the acetone extract ranged from 114.00 ± 3.43 to 205.33 ± 1.78 mg GAE/g DW, for ethanol varied from 39.93 ± 4.61 to 148.87 ± 3.76 mg GAE/g DW, and for methanol from 52.33 ± 1.61 to 207.44 ± 2.07 mg GAE/g DW. The aqueous extract TPC ranged from 52.24 ± 0.89 to 169.80 ± 1.94 mg GAE/g DW. The authors noted that the ethanol extract exhibited the highest antioxidant activities and antibacterial effects against B. cereus, E. coli, S. aureus, and Y. enterocolitica. In contrast, Listeria monocytogenes and Salmonella showed greater sensitivity to the acetone extract of myrtle berries. In terms of antioxidant activity, Pereira et al. [43] described that their UAE extract exhibited higher antioxidant activity compared to their SFE extract. The authors associated these results with the greater quantity of extracted phytochemicals with antioxidant properties, such as flavonoids, in the UAE extract as opposed to the compound selectivity observed in supercritical extraction.
When comparing the findings reported in the literature, one possible explanation for the differences in TPC in our UAE extract may be due to the higher extraction yield achieved by adding acetic acid to modify the solvent’s polarity. Additionally, the extraction time plays a significant role; most studies in the literature utilized an extraction method that involves at least 8 h of solid–liquid maceration. The phytochemical composition of plants extracts can vary due to several factors, including the extraction method, protocols used for the characterization, environmental conditions, and geographical location where the plants grow.
Several published works have reported identified and quantified phytochemical compounds from the myrtle berries extracts. For instance, Babou et al. [44] reported from their HPLC-DAD analyses of mature myrtle berries aqueous and hydro methanolic extract compounds like phenols acids (gallic acid and ellagic acid), flavonoids (isomers of myricetin, isomers of quercetin, and kaempferol), anthocyanins (delphinidin-3-O-glucoside and malvidin-3-O-glucoside). Compounds like gallic acid (4.54 ± 0.07–1.21 ± 0.02 mg/g DW), malvidin-3-O-glucoside (0.30 ± 0.03–0.32 ± 0.01 mg/g DW), and quercetin and its isomers (ranging between 1.05 and 1.32 mg/g DW) also detected in our extract’s characterization were found in higher contents in the UAE and/or SFE extracts. Similar to the case of Curiel et al. [47], the contents of gallic acid (0.17 ± 0.03 mg/g DW) and quercetin (0.20 ± 0.01 mg/g DW) reported from HPLC analyses of an acidified myrtle berries aqueous homogenate were lower compared to the gallic acid content quantified in our UAE and SFE extracts. Other compounds identified and quantified by the authors consisted of vanillic acid (0.10 ± 0.02 mg/g DW), syringic acid (0.14 ± 0.04 mg/g DW), ellagic acid (1.44 ± 0.03 mg/g DW), myricetin (1.11 ± 0.02 mg/g DW), and catechin (1.12 ± 0.02 mg/g DW). The research realized by D’Urso et al. [49] provides a diverse range of phytochemical compounds present in Myrtus communis berries using HPLC-ESI-Orbitrap-MS/MS analysis in both negative and positive ion modes. The research team reported the presence of hydrolyzable tannins, including HHDP-hexose, monogalloylhexose, strictinin (galloyl-HHDP hexose), galloylquinic acid, tellimagrandin I, punicalin, and pedunculagin (Bis HHDP hexose). Additional compounds included casuarictin, castalagin, tellimagrandin II (Trigalloyl HHDP hexose), ellagic acid hexoside, and ellagic acid. The team also identified gallomyrtucommulones, specifically gallomyrtucommulone C, as well as hydroxycinnamic acids like caffeoylhexose. Flavanols such as epigallocatechin, catechin/epicatechin, myricetin (in the forms of galloylhexoside, hexoside, pentoside, deoxyhexoside, galloyl deoxyhexose, and hexose deoxyhexose), alongside quercetin (in galloylhexoside and hexoside forms). In addition, the anthocyanins included petunidin pentoside, and in both formes they detected hexoside and pentoside of delphinidin, cyanidin, peonidin, and malvidin. Some of the mentioned compounds were also identified and quantified in our extracts of myrtle berries from the UAE and SFE methods.
The spectrophotometric characterization in our study indicates a higher TPC compared to the identification and quantification of polyphenolic compounds using RP-HPLC. The previous literature has noted that spectrophotometric assays, particularly those using the Folin–Ciocâlteu reagent, can overestimate the total phenolic content. This discrepancy may occur due to the interference of non-phenolic compounds, such as sugars, aromatic amines, ascorbic acid, sulfur dioxide, and certain inorganic substances [48,49,50]. Regarding the TAC measured by spectrophotometric means based on the pH differential protocol, it appears not to be a sensitive assay for the SFE extract. The RP-HPLC characterization of the SFE extract successfully identified and quantified four anthocyanin compounds, although in low concentrations. Anthocyanins are polar compounds generally extracted utilizing acidified solvents by adding organic or mineral acids. In lower pH conditions, anthocyanins are in their stable flavylium form [51]. In supercritical extraction conditions, CO2 acts as a lipophilic solvent, and the addition of ethanol as a co-solvent in the supercritical extraction contributed to extracting low contents of anthocyanin compounds. However, anthocyanins have been reported to be successfully extracted by supercritical extraction from different vegetal matrices such as roselle calyces [52], haskap berry [53], and blueberry [54].
α-Amylase is an enzyme that hydrolyzes α-1,4 glycosidic bonds in carbohydrate polymers, such as starch, breaking them down into shorter oligomers like maltose, dextrin, and maltotriose. In humans, this enzyme is present in saliva and pancreatic juice. The products of α-amylase hydrolysis serve as substrates for α-glucosidase, which then produces glucose. Inhibiting the activities of these enzymes can effectively slow down the rate of starch hydrolysis, helping to control postprandial hyperglycemia. Many diabetes medications aim to restrict carbohydrate digestion and absorption. Some commonly used enzyme inhibitors in clinical treatment are acarbose, miglitol, and voglibose. However, the effectiveness of these medications is often accompanied by undesirable side effects, including abdominal distention, flatulence, meteorism, and diarrhea. Due to these significant side effects, researchers are exploring alternative therapies that have minimal or no harmful effects. Herbal therapies, in particular, appear to be effective while exhibiting fewer side effects, making them a cost-effective alternative to conventional hypoglycemic medications [55,56]. An IC50 of 3.91 ± 0.44 µg/mL for acarbose against α-amylase was reported by Serea et al. [39] using the same protocol applied to assess the antidiabetic activity of the myrtle extracts used in this study. Among the two extracts, the UAE extract exhibited the lowest IC50 at 8.37 ± 0.52 µg/mL DW, indicating potent inhibition of α-amylase activity. By inhibiting the enzymatic activity of α-amylase, the substrate availability for α-glucosidase hydrolysis would be significantly reduced, making the myrtle berry extract a promising alternative for controlling postprandial hyperglycemia.
Several published works have been conducted regarding the antibacterial properties of myrtle leaves and berries. For the antibacterial activity of the myrtle berries essential oil, performed using the disk diffusion method, DIZ values of 14.00 ± 0.65 mm for B. subtilis (ATCC 11778), 20.00 ± 0.20 mm for E. coli (ATCC 25922), and 19.50 ± 1.13 mm for S. aureus (ATCC 25923) were reported [57]. Another study utilizing an aqueous extract from myrtle berries seeds for the antibacterial activity against B. cereus (ATCC 1247), E. coli (ATCC 8739), and S. aureus (ATCC 29213) showed diameter of inhibition zones of 17 ± 0.8 mm, 18 ± 0.8 mm, and 14 ± 0.9 mm, respectively [58]. When comparing the antibacterial activity reported in the literature, the results fall within a similar range of inhibition. The differences observed can be attributed to factors such as the extraction method, the solubilization solution used for antibacterial assessment, the inoculum size, and the specific bacterial subspecies tested.
The SFE method offers the advantage of producing extracts that require minimal concentration processing. Ethanol and water were used as co-solvents in our work—considered as green solvents—and the extraction process leaves behind a dry by-product (or groats) that can be used for other applications, thus reducing environmental impact. Additionally, valorization of the myrtle berry by-product obtained from the SFE method could be a valuable topic for future research. Pure CO2 is inexpensive, and its recirculation in the system provides cost benefits. However, optimization tests are necessary to achieve higher extraction yields and selectivity for specific desired compounds. Similarly, optimization of the UAE method is needed to maximize the extraction of the specific compounds while minimizing extraction time. The recovery of the solvent used in solid–liquid extraction can also reduce process costs. Considering its implementation at an industrial scale, both extraction methods present benefits and challenges.
5. Conclusions
Our study investigated the polyphenolic content; phytochemical characterization through RP-HPLC; and the antioxidant, antidiabetic, and antibacterial potential of wild myrtle berries collected in Albania using two extraction methods.
The solid–liquid ultrasound-assisted extraction (UAE) method with acidified ethanol demonstrated a high extraction yield, along with elevated contents of total flavonoids and anthocyanins, and exhibited notable antidiabetic activity. On the other hand, the supercritical fluid extraction (SFE) resulted in a higher total phenolic content and antioxidant activity, as measured by the DPPH radical screening assay. RP-HPLC characterization successfully identified and quantified several phytochemical compounds, including phenolic acids, terpenoids, flavonoids, and anthocyanins from both the UAE and SFE extracts, as well as lipophilic compounds from the SFE extract. Both extraction methods displayed similar antimicrobial activity against the tested strains. The results obtained in this work support the potential of Myrtus communis berries extracts as an ingredient in functional food mainly for their antioxidant, antidiabetic, and antibacterial properties.
The findings of this study highlight the impact of the extraction method on the profile of bioactive compounds, which is crucial when selecting a technique for specific applications, such as antioxidant, antidiabetic, or antibacterial purposes. The UAE method appears to be more effective in extracting a wide range of phytochemical compounds, while SFE captures a more limited but distinct profile of bioactive compounds that may be of particular interest.
Author Contributions
Conceptualization, L.M., N.S., and I.M.; methodology, N.S., L.M., M.C., M.T., G.C., and I.M.; software, I.M., G.C., M.C., and M.T.; validation, N.S.; formal analysis, I.M., M.C., M.T., and N.B.; investigation, I.M., M.C., M.T., and N.B.; resources, N.S., G.R., and L.M.; writing—original draft preparation, I.M.; writing—review and editing, I.M., L.M., and G.C.; visualization, L.M., I.M., and G.C.; supervision, L.M.; funding acquisition, N.S., G.R., and L.M. All authors have read and agreed to the published version of the manuscript.
Funding
The authors are grateful for the financial support offered by the SINOVEG project, SMIS cod 119659, contract no. 326/390002/31.10.2020, financed by POC (COP/163/1/3), Action 1.2.1: Innovative Technological Project.
Data Availability Statement
The data will be available upon request.
Acknowledgments
The Integrated Center for Research, Expertise, and Technological Transfer in Food Industry is acknowledged for providing technical support. The first author also wants to thank Dhimitër Mërtiri and Hatixhe Mërtiri for their contributions to the plant material collection and cleaning process.
Conflicts of Interest
The authors declare no conflicts of interest.
References
- Sumbul, S.; Ahmad, M.; Asif, M.; Akhtar, M. Myrtus communis Linn.—A Review. Indian. J. Nat. Prod. Resour. 2011, 2, 395–402. [Google Scholar]
- Al-Snafi, A.E.; Teibo, J.O.; Shaheen, H.M.; Akinfe, O.A.; Teibo, T.K.A.; Emieseimokumo, N.; Elfiky, M.M.; Al-kuraishy, H.M.; Al-Garbeeb, A.I.; Alexiou, A.; et al. The Therapeutic Value of Myrtus communis L.: An Updated Review. Naunyn-Schmiedeberg’s Arch. Pharmacol. 2024, 397, 4579–4600. [Google Scholar] [CrossRef]
- Hennia, A.; Nemmiche, S.; Dandlen, S.; Miguel, M.G. Myrtus communis Essential Oils: Insecticidal, Antioxidant and Antimicrobial Activities: A Review. J. Essent. Oil Res. 2019, 31, 487–545. [Google Scholar] [CrossRef]
- Medda, S.; Mulas, M. Fruit Quality Characters of Myrtle (Myrtus communis L.) Selections: Review of a Domestication Process. Sustainability 2021, 13, 8785. [Google Scholar] [CrossRef]
- Tuberoso, C.I.G.; Melis, M.; Angioni, A.; Pala, M.; Cabras, P. Myrtle Hydroalcoholic Extracts Obtained from Different Selections of Myrtus communis L. Food Chem. 2007, 101, 806–811. [Google Scholar] [CrossRef]
- Mashhadi, H.; Nourabi, A.; Mohammadi, M.; Tabibiazar, M.; Varvani Farahani, A. Incorporation of Myrtle Essential Oil into Hydrolyzed Ethyl Cellulose Films for Enhanced Antimicrobial Packaging Applications 2023. Food Biosci. 2024, 62, 105029. [Google Scholar] [CrossRef]
- Zam, W.; Ali, A. Evaluation of Mechanical, Antioxidant and Antimicrobial Properties of Edible Film Containing Myrtle Berries Extract. Nat. Prod. J. 2018, 8, 323–330. [Google Scholar] [CrossRef]
- Ali, A.; Zam, W.; Ibrahim, W. Formulation and Evaluation of Chewable Lozenges Containing Myrtle Berries, Cinnamon and Cloves for Oral Disinfection. J. Stem Cell Ther. Res. 2022, 1, 1–8. [Google Scholar]
- De Luca, M.; Lucchesi, D.; Tuberoso, C.I.G.; Fernàndez-Busquets, X.; Vassallo, A.; Martelli, G.; Fadda, A.M.; Pucci, L.; Caddeo, C. Liposomal Formulations to Improve Antioxidant Power of Myrtle Berry Extract for Potential Skin Application. Pharmaceutics 2022, 14, 910. [Google Scholar] [CrossRef]
- Haririan, Y.; Asefnejad, A.; Hamishehkar, H.; Farahpour, M.R. Carboxymethyl Chitosan-Gelatin-Mesoporous Silica Nanoparticles Containing Myrtus communis L. Extract as a Novel Transparent Film Wound Dressing. Int. J. Biol. Macromol. 2023, 253, 127081. [Google Scholar] [CrossRef] [PubMed]
- Wissam, Z. Wound Dressings Uploaded with Myrtle Berries Extract and Nigella Sativa Honey. Univers. J. Pharm. Res. 2018, 3, 12–16. [Google Scholar] [CrossRef][Green Version]
- Correddu, F.; Fancello, F.; Chessa, L.; Atzori, A.S.; Pulina, G.; Nudda, A. Effects of Supplementation with Exhausted Myrtle Berries on Rumen Function of Dairy Sheep. Small Rumin. Res. 2019, 170, 51–61. [Google Scholar] [CrossRef]
- Al-Maharik, N.; Jaradat, N.; Al-Hajj, N.; Jaber, S. Myrtus communis L.: Essential Oil Chemical Composition, Total Phenols and Flavonoids Contents, Antimicrobial, Antioxidant, Anticancer, and α-Amylase Inhibitory Activity. Chem. Biol. Technol. Agric. 2023, 10, 41. [Google Scholar] [CrossRef]
- Aleksic, V.; Knezevic, P. Antimicrobial and Antioxidative Activity of Extracts and Essential Oils of Myrtus communis L. Microbiol. Res. 2014, 169, 240–254. [Google Scholar] [CrossRef]
- Dabbaghi, M.M.; Fadaei, M.S.; Soleimani Roudi, H.; Baradaran Rahimi, V.; Askari, V.R. A Review of the Biological Effects of Myrtus communis. Physiol. Rep. 2023, 11, e15770. [Google Scholar] [CrossRef]
- Awad, A.M.; Kumar, P.; Ismail-Fitry, M.R.; Jusoh, S.; Ab Aziz, M.F.; Sazili, A.Q. Green Extraction of Bioactive Compounds from Plant Biomass and Their Application in Meat as Natural Antioxidant. Antioxidants 2021, 10, 1465. [Google Scholar] [CrossRef]
- Jha, A.K.; Sit, N. Extraction of Bioactive Compounds from Plant Materials Using Combination of Various Novel Methods: A Review. Trends Food Sci. Technol. 2022, 119, 579–591. [Google Scholar] [CrossRef]
- Alara, O.R.; Abdurahman, N.H.; Ukaegbu, C.I. Extraction of Phenolic Compounds: A Review. Curr. Res. Food Sci. 2021, 4, 200–214. [Google Scholar] [CrossRef]
- Bitwell, C.; Indra, S.S.; Luke, C.; Kakoma, M.K. A Review of Modern and Conventional Extraction Techniques and Their Applications for Extracting Phytochemicals from Plants. Sci. Afr. 2023, 19, e01585. [Google Scholar] [CrossRef]
- Martins, R.; Barbosa, A.; Advinha, B.; Sales, H.; Pontes, R.; Nunes, J. Green Extraction Techniques of Bioactive Compounds: A State-of-the-Art Review. Processes 2023, 11, 2255. [Google Scholar] [CrossRef]
- Ojha, K.S.; Aznar, R.; O’Donnell, C.; Tiwari, B.K. Ultrasound Technology for the Extraction of Biologically Active Molecules from Plant, Animal and Marine Sources. TrAC Trends Anal. Chem. 2020, 122, 115663. [Google Scholar] [CrossRef]
- Majid, I.; Khan, S.; Aladel, A.; Dar, A.H.; Adnan, M.; Khan, M.I.; Mahgoub Awadelkareem, A.; Ashraf, S.A. Recent Insights into Green Extraction Techniques as Efficient Methods for the Extraction of Bioactive Components and Essential Oils from Foods. CyTA-J. Food 2023, 21, 101–114. [Google Scholar] [CrossRef]
- Brondz, I.; Sedunov, B.; Sivaraman, N. Influence of Modifiers on Supercritical Fluid Chromatography (SFC) and Supercritical Fluid Extraction (SFE), Part I. Int. J. Anal. Mass. Spectrom. Chromatogr. 2017, 5, 17–39. [Google Scholar] [CrossRef][Green Version]
- Yıldırım, M.; Erşatır, M.; Poyraz, S.; Amangeldinova, M.; Kudrina, N.O.; Terletskaya, N.V. Green Extraction of Plant Materials Using Supercritical CO2: Insights into Methods, Analysis, and Bioactivity. Plants 2024, 13, 295. [Google Scholar] [CrossRef] [PubMed]
- Chuo, S.C.; Nasir, H.M.; Mohd-Setapar, S.H.; Mohamed, S.F.; Ahmad, A.; Wani, W.A.; Muddassir, M.; Alarifi, A. A Glimpse into the Extraction Methods of Active Compounds from Plants. Crit. Rev. Anal. Chem. 2022, 52, 667–696. [Google Scholar] [CrossRef] [PubMed]
- Essien, S.O.; Young, B.; Baroutian, S. Recent Advances in Subcritical Water and Supercritical Carbon Dioxide Extraction of Bioactive Compounds from Plant Materials. Trends Food Sci. Technol. 2020, 97, 156–169. [Google Scholar] [CrossRef]
- Medda, S.; Fadda, A.; Dessena, L.; Mulas, M. Quantification of Total Phenols, Tannins, Anthocyanins Content in Myrtus communis L. and Antioxidant Activity Evaluation in Function of Plant Development Stages and Altitude of Origin Site. Agronomy 2021, 11, 1059. [Google Scholar] [CrossRef]
- Mihalcea, L.; Turturică, M.; Cucolea, E.I.; Dănilă, G.-M.; Dumitrașcu, L.; Coman, G.; Constantin, O.E.; Grigore-Gurgu, L.; Stănciuc, N. CO2 Supercritical Fluid Extraction of Oleoresins from Sea Buckthorn Pomace: Evidence of Advanced Bioactive Profile and Selected Functionality. Antioxidants 2021, 10, 1681. [Google Scholar] [CrossRef]
- Ghasemi, E.; Raofie, F.; Najafi, N.M. Application of Response Surface Methodology and Central Composite Design for the Optimisation of Supercritical Fluid Extraction of Essential Oils from Myrtus communis L. Leaves. Food Chem. 2011, 126, 1449–1453. [Google Scholar] [CrossRef]
- Idris Sitinoor Adeib, Masturah Markom, Norliza Abd Rahman, Jarinah Mohd Ali, Prediction of overall yield of Gynura procumbens from ethanol-water + supercritical CO2 extraction using artificial neural network model. Case Stud. Chem. Environ. Eng. 2022, 5, 100175. [CrossRef]
- Duran, R.R.; Falsetti, P.E.; Muhr, L.; Privat, R.; Barth, D. Phase Equilibrium Study of the Ternary System CO2 + H2O + Ethanol At Elevated Pressure: Thermodynamic Model Selection. Application to Supercritical Extraction of Polar Compounds. J. Supercrit. Fluids 2018, 138, 17–28. [Google Scholar] [CrossRef]
- Pereira, P.; Cebola, M.-J.; Oliveira, M.C.; Bernardo-Gil, M.G. Supercritical Fluid Extraction vs. Conventional Extraction of Myrtle Leaves and Berries: Comparison of Antioxidant Activity and Identification of Bioactive Compounds. J. Supercrit. Fluids 2016, 113, 1–9. [Google Scholar] [CrossRef]
- Pereira, P.; Mauricio, E.M.; Duarte, M.P.; Lima, K.; Fernandes, A.S.; Bernardo-Gil, G.; Cebola, M.-J. Potential of Supercritical Fluid Myrtle Extracts as an Active Ingredient and Co-Preservative for Cosmetic and Topical Pharmaceutical Applications. Sustain. Chem. Pharm. 2022, 28, 100739. [Google Scholar] [CrossRef]
- Radzali, S.A.; Markom, M.; Saleh, N.M. Co-Solvent Selection for Supercritical Fluid Extraction (SFE) of Phenolic Compounds from Labisia pumila. Molecules 2020, 25, 5859. [Google Scholar] [CrossRef] [PubMed]
- Stoica, F.; Condurache, N.N.; Horincar, G.; Constantin, O.E.; Turturică, M.; Stănciuc, N.; Aprodu, I.; Croitoru, C.; Râpeanu, G. Value-Added Crackers Enriched with Red Onion Skin Anthocyanins Entrapped in Different Combinations of Wall Materials. Antioxidants 2022, 11, 1048. [Google Scholar] [CrossRef]
- Yangui, I.; Younsi, F.; Ghali, W.; Boussaid, M.; Messaoud, C. Phytochemicals, Antioxidant and Anti-Proliferative Activities of Myrtus communis L. Genotypes from Tunisia. S. Afr. J. Bot. 2021, 137, 35–45. [Google Scholar] [CrossRef]
- PubChem Cyanidin 3-Glucoside. Available online: https://pubchem.ncbi.nlm.nih.gov/compound/12303220 (accessed on 12 February 2024).
- Mërtiri, I.; Păcularu-Burada, B.; Stănciuc, N. Phytochemical Characterization and Antibacterial Activity of Albanian Juniperus Communis and Juniperus Oxycedrus Berries and Needle Leaves Extracts. Antioxidants 2024, 13, 345. [Google Scholar] [CrossRef]
- Serea, D.; Condurache, N.N.; Aprodu, I.; Constantin, O.E.; Bahrim, G.-E.; Stănciuc, N.; Stanciu, S.; Rapeanu, G. Thermal Stability and Inhibitory Action of Red Grape Skin Phytochemicals against Enzymes Associated with Metabolic Syndrome. Antioxidants 2022, 11, 118. [Google Scholar] [CrossRef]
- Hannan, A.; Asghar, S.; Tahir, N.; Ikram Ullah, M.; Ahmed, I.; Aneela, S.; Hussain, S. Antibacterial Effect of Mango (Mangifera indica Linn.) Leaf Extract against Antibiotic Sensitive and Multi-Drug Resistant Salmonella Typhi. Pak. J. Pharm. Sci. 2013, 26, 715–719. [Google Scholar]
- Masota, N.E.; Vogg, G.; Ohlsen, K.; Holzgrabe, U. Reproducibility Challenges in the Search for Antibacterial Compounds from Nature. PLoS ONE 2021, 16, e0255437. [Google Scholar] [CrossRef]
- Bhavya, M.L.; Chandu, A.G.S.; Devi, S.S.; Quirin, K.-W.; Pasha, A.; Vijayendra, S.V.N. In-Vitro Evaluation of Antimicrobial and Insect Repellent Potential of Supercritical-Carbon Dioxide (SCF-CO2) Extracts of Selected Botanicals against Stored Product Pests and Foodborne Pathogens. J. Food Sci. Technol. 2020, 57, 1071–1079. [Google Scholar] [CrossRef]
- Pereira, P.; Cebola, M.-J.; Oliveira, M.C.; Bernardo Gil, M.G. Antioxidant Capacity and Identification of Bioactive Compounds of Myrtus communis L. Extract Obtained by Ultrasound-Assisted Extraction. J. Food Sci. Technol. 2017, 54, 4362–4369. [Google Scholar] [CrossRef]
- Babou, L.; Hadidi, L.; Grosso, C.; Zaidi, F.; Valentão, P.; Andrade, P.B. Study of Phenolic Composition and Antioxidant Activity of Myrtle Leaves and Fruits as a Function of Maturation. Eur. Food Res. Technol. 2016, 242, 1447–1457. [Google Scholar] [CrossRef]
- Jerkovic, I.; Radonic, A.; Borcic, I. Comparative Study of Leaf, Fruit and Flower Essential Oils of Croatian Myrtus communis (L.) During a One-Year Vegetative Cycle. J. Essent. Oil Res. 2002, 14, 266–270. [Google Scholar] [CrossRef]
- Amensour, M.; Sendra, E.; Abrini, J.; Bouhdid, S.; Pérez-Alvarez, J.A.; Fernández-López, J. Total Phenolic Content and Antioxidant Activity of Myrtle (Myrtus communis) Extracts. Nat. Prod. Commun. 2009, 4, 1934578X0900400. [Google Scholar] [CrossRef]
- Curiel, J.A.; Pinto, D.; Marzani, B.; Filannino, P.; Farris, G.A.; Gobbetti, M.; Rizzello, C.G. Lactic Acid Fermentation as a Tool to Enhance the Antioxidant Properties of Myrtus communis Berries. Microb. Cell Factories 2015, 14, 67. [Google Scholar] [CrossRef]
- Polat, B.; Oba, S.; Karaman, K.; Arici, M.; Sagdic, O. Comparison of Different Solvent Types for Determination Biological Activities of Myrtle Berries Collected from Turkey. Qual. Assur. Saf. Crops Foods 2014, 6, 221–227. [Google Scholar] [CrossRef]
- D’Urso, G.; Sarais, G.; Lai, C.; Pizza, C.; Montoro, P. LC-MS Based Metabolomics Study of Different Parts of Myrtle Berry from Sardinia (Italy). JBR 2017, 7, 217–229. [Google Scholar] [CrossRef]
- Antony, A.; Farid, M. Effect of Temperatures on Polyphenols during Extraction. Appl. Sci. 2022, 12, 2107. [Google Scholar] [CrossRef]
- Alappat, B.; Alappat, J. Anthocyanin Pigments: Beyond Aesthetics. Molecules 2020, 25, 5500. [Google Scholar] [CrossRef]
- Idham, Z.; Putra, N.R.; Aziz, A.H.A.; Zaini, A.S.; Rasidek, N.A.M.; Mili, N.; Yunus, M.A.C. Improvement of Extraction and Stability of Anthocyanins, the Natural Red Pigment from Roselle Calyces Using Supercritical Carbon Dioxide Extraction. J. CO2 Util. 2022, 56, 101839. [Google Scholar] [CrossRef]
- Jiao, G.; Kermanshahi Pour, A. Extraction of Anthocyanins from Haskap Berry Pulp Using Supercritical Carbon Dioxide: Influence of Co-Solvent Composition and Pretreatment. LWT 2018, 98, 237–244. [Google Scholar] [CrossRef]
- Paes, J.; Dotta, R.; Barbero, G.F.; Martínez, J. Extraction of Phenolic Compounds and Anthocyanins from Blueberry (Vaccinium myrtillus L.) Residues Using Supercritical CO2 and Pressurized Liquids. J. Supercrit. Fluids 2014, 95, 8–16. [Google Scholar] [CrossRef]
- Li, X.; Bai, Y.; Jin, Z.; Svensson, B. Food-Derived Non-Phenolic α-Amylase and α-Glucosidase Inhibitors for Controlling Starch Digestion Rate and Guiding Diabetes-Friendly Recipes. LWT 2022, 153, 112455. [Google Scholar] [CrossRef]
- Kashtoh, H.; Baek, K.-H. New Insights into the Latest Advancement in α-Amylase Inhibitors of Plant Origin with Anti-Diabetic Effects. Plants 2023, 12, 2944. [Google Scholar] [CrossRef]
- Toauibia, M. Antimicrobial Activity of the Essential Oil of Myrtus communis L. Berries Growing Wild in Algeria. J. Fundam. Appl. Sci. 2015, 7, 150. [Google Scholar] [CrossRef]
- Jabri, M.-A.; Rtibi, K.; Ben-Said, A.; Aouadhi, C.; Hosni, K.; Sakly, M.; Sebai, H. Antidiarrhoeal, Antimicrobial and Antioxidant Effects of Myrtle Berries (Myrtus communis L.) Seeds Extract. J. Pharm. Pharmacol. 2016, 68, 264–274. [Google Scholar] [CrossRef]
Disclaimer/Publisher’s Note: The statements, opinions and data contained in all publications are solely those of the individual author(s) and contributor(s) and not of MDPI and/or the editor(s). MDPI and/or the editor(s) disclaim responsibility for any injury to people or property resulting from any ideas, methods, instructions or products referred to in the content. |
© 2025 by the authors. Licensee MDPI, Basel, Switzerland. This article is an open access article distributed under the terms and conditions of the Creative Commons Attribution (CC BY) license (https://creativecommons.org/licenses/by/4.0/).